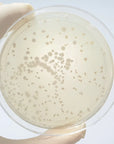

Probio 4 mld - Integratore a base naturale
CONSIGLIATO CON
SPECIFICHE PRODOTTO
Le liste ingredienti, le modalità d'uso e le avvertenze possono subire variazioni, si deve fare riferimento al packaging del prodotto per la versione più aggiornata. Le informazioni qui presentate sono frutto della nostra esperienza e non sostituiscono in alcun modo il parere del medico. È importante evitare l'autoterapia.
La natura è l'essenza di ciò che facciamo
Scopri i prodotti più amati e consigliati dai nostri clienti
